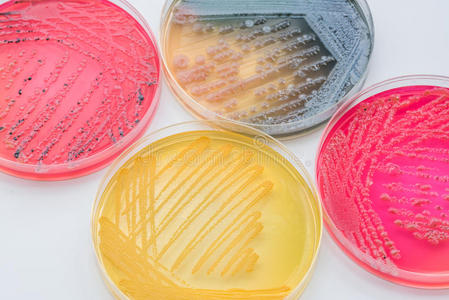
我姓辛在选择性琼脂培养基xlt琼脂(xy)上培养细菌菌落照片

细菌培养基

lb培养基
图片尺寸2560x1440
细菌总数显色培养基
图片尺寸700x1025
1.准备培养基(里面装上牛肉汤)
图片尺寸600x450
r2a琼脂培养基中国药典
图片尺寸3364x3364
在鉴别和选择性培养基上培养细菌菌落照片
图片尺寸449x300
志贺氏菌显色培养基平板9cm培养皿科玛嘉原料细菌培养皿 十个2f包
图片尺寸800x800
thermo赛默飞世尔 其它细菌培养基
图片尺寸1077x1122
培养基中生长的微生物多种多样,期中细菌菌落一般较小,多呈白色画淡
图片尺寸2667x2000
坂崎杆菌显色培养基.jpg
图片尺寸2816x2112
水平板计数琼脂培养基微生物质控结果:用途:用于水中微生物细菌总数
图片尺寸1000x1000
pca平板计数培养基上的,是细菌吗?
图片尺寸4032x3024
杆菌有黄色色素金黄色葡萄球菌不同细菌在接触皿培养基上的生长特征
图片尺寸2778x2778
细菌总数显色培养基
图片尺寸628x624
制作lb培养基,并检测(培养)手上de细菌.
图片尺寸1080x1915
用蛋白胨牛肉膏培养基培养出来的片状菌是什么菌
图片尺寸1500x1125
mrs培养基的细菌形态
图片尺寸4160x3120
用途:用于海生细菌的增菌培养.
图片尺寸1000x1263
我姓辛在选择性琼脂培养基xlt琼脂(xy)上培养细菌菌落照片
图片尺寸449x300
菌有黄色色素金黄色葡萄球菌不同细菌在tsa培养基平板上的生长特征
图片尺寸1000x1000
细菌在固体培养基上的生长现象 细菌固体培养基
图片尺寸1200x801